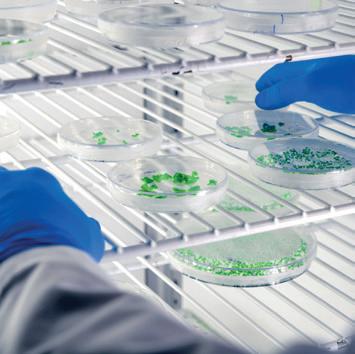

Ridium ®
Skin Algae THERAPY

©️ Xelliss. All rights reserved. Any reproduction in whole or in part is illegal. The same applies to translation, adaptation or transformation, layout or reproduction by any art or process whatsoever. Non-contractual visuals. Photo credits: Xelliss, Pexels, Istock and Freepik.com
Ridium ®
Skin Algae
THERAPY
The world of microalgae provides a source of inspiration for the development of our «New Generation Cosmetics» range.
We employ our state-of-the-art biotechnology processes to produce the natural active ingredients that will be used to develop the formulas of our cosmetics products. In our laboratories, we cultivate our own microalgae in photobioreactors in order to produce and concentrate nature’s bioactive ingredients.
Indeed, several species of microalgae have very attractive biosynthesis specificities for skincare applications and benefits for the skin.
Xelliss became interested in the microalgae Porphyridium cruentum in the course of its scientific research in the marine world, developing an expertise on its natural protective properties against oxidation and cellular damage.
As a result, Xelliss is innovating by creating a unique product in the world of luxury cosmetics: Ridium®
The creation of this premium cosmetic treatment Ridium® has therefore incorporated the active ingredient used by the microalgae Porphyridium cruentum for survival in extreme environments. This natural molecule is a polysaccharide that acts, as it does for the microalgae, as a protective shield for your skin against external aggressions. Thanks to an exceptional concentration, 99% active ingredient, the application of Ridium® gives you an immediate micro-lifting effect as well as long-term regenerating and repairing effects for your skin.
Over the following pages, I invite you to discover our revolutionary innovation Ridium®, Skin Algae Therapy
Jimmy Wan VP - Xelliss Director of Operations
Contents
Microalgae
Polysaccharides
Porphyridium cruentum
A biotech production process
Benefits of the active ingredient found in Porphyridium cruentum
Sulphated polysaccharides from Porphyridium cruentum
Ridium®
Xelliss’ technological process
Ridium® and its actions
Scientific evidence - Ridium®
How to use Ridium®


Microalgae, SMALL UNICELLULAR FACTORIES CAPABLE OF BIOSYNTHESIZING A WIDE VARIETY OF NATURAL ACTIVE INGREDIENTS FOR USE IN COSMETICS
Among marine organisms, microalgae are considered one of the best sources of compounds of interest to various industrial sectors, thanks to their many properties. Their secondary metabolites belong to diverse chemical families, such as lipids, polysaccharides, pigments and amino acids.
Microalgae have developed unique metabolic capacities to ensure their survival in varied, sometimes very hostile environments, requiring the biosynthesis of a wide variety of secondary metabolites with noteworthy bioactivities.
The biological activities of microalgae in cosmetics, medicine and nutrition are highlighted in numerous research and scientific publications. Some of these activities have been approved by health organizations such as WHO (World Health Organization), EFSA (European Food Safety Authority), FDA (Food and Drug Administration) and many others, confirming the immense potential of these marine or aquatic microorganisms.
Polysaccharides
SUGAR POLYMERS, MICROALGAE TREASURES
Some microalgae secrete polysaccharides, the chemical structure of which varies according to the species of microalgae in question, allowing them not only to survive but also to grow and regenerate when exposed to austere environments.
Scientists have evaluated the polysaccharides through scientific testing and have proven that these compounds help protect and regenerate the microalgae cell.
This research has subsequently made it possible to develop their uses.
These polysaccharides have advantages over those obtained by chemical synthesis because they have better rheological, physico-chemical and biochemical characteristics.
As a result, these ingredients of marine or aquatic origin are particularly sought-after by various sectors because they are more stable in terms of pH and temperature.
The cosmetics industry is one of the most interested, as evidenced by the appearance on the market of various skincare products derived from these natural ingredients.

extreme conditions (light radiation, pH, salinity). They are capable of producing many active compounds such as sulphated polysaccharides, pigments and polyunsaturated fatty acids.


A unique combination of pigments, vitamins, lipids and polysaccharides provides natural protection against oxidation and cellular damage. Their survival under these conditions is attributed, for example, to the shield of specific polysaccharides excreted by the cells into the growth medium, creating a gel-like, protective and truly effective surrounding environment.

A biotech production process
PATENTED TECHNOLOGY FOR THE PRODUCTION OF BIOACTIVES
Xelliss has developed a biotech process for the production of active ingredients derived from the microalgae Porphyridium cruentum in photobioreactors, providing a purity and quality of active ingredient suitable for use in its «New Generation» cosmetics line.

Cultivation takes place in a closed system that is monitored for all growth parameters, in the presence of the strain in its pure state, without contamination by cells of other species.
capacity is thereby cultivated in sea water (microalgae of marine origin), to which are added the nutritional elements essential for cell growth and the biosynthesis of active ingredients such as CO2, nitrate and phosphate. In this way, by means of the light energy provided, the cells will transform the carbon source «CO2» and will fix it in the molecules of the sugars that make up the polysaccharides.
The microalgae Porphyridium cruentum is extremely delicate and its cultivation must be perfectly controlled in order to obtain the desired metabolite production. In the case of sulphated polysaccharide biosynthesis, it is stimulated by a change in parameters applied to the cells after growth, during the stationary phase. Part of the polysaccharides biosynthesized in
this way are excreted into the medium as exopolysaccharides (EPS), and their accumulation during the stationary phase of development makes the culture medium highly viscous.
The algae cells are physically separated from the water by means of a purification process. The soluble polysaccharide is then purified from the water. At the end of the process, a pure off-white hydrogel is obtained; its viscosity and polysaccharide content are controlled to guarantee optimal quality.
Its production and purification process is completely natural, without any additives, solvents or other reagents. The product comprises solely the dissolved and purified polysaccharide, collected in the water in which the algae live.


Benefits of the active ingredient found in Porphyridium cruentum
SKIN HEALTH AND ITS ENVIRONMENT
Epidermis
Dermoepidermal junction
The skin acts as a protective barrier by isolating our body from its environment and helping to maintain the integrity of all internal structures, which can simultaneously serve as a communication system with the external environment.
However, beyond its biological function, the skin plays an important role in an individual’s health. Biochemical changes, which are triggered by the ageing process in addition to external agents, induce damage to the skin such as the appearance of wrinkles, age spots, loss of elasticity and firmness, inflammation and thinning of the dermal matrix.
Dermis
Hypodermis



The main biochemical imbalance produced is an increased activity of enzymes such as collagenase, elastase and hyaluronidase. This leads to an accelerated deterioration of the three main components of the skin: collagen (protein responsible for firmness), elastin (protein that provides elasticity) and hyaluronic acid (glycosaminoglycan, which generates volume thanks to water retention).
Another important alteration caused by ageing and by certain environmental factors (pollution, solar radiation, climatic conditions, among others...) is the powerful generation of reactive oxygen species (ROS), such as the hydroxyl radical and the superoxide anion, which are involved in mutagenesis, carcinogenesis and ageing itself.
For this reason, various substances have been studied for several decades to find out their capacity to inhibit collagenase, elastase and hyaluronidase. When they show significant inhibitory activity, they can be used as active ingredients in cosmetic and pharmaceutical formulations.
Epidermis
Collagen
Elastin
Healthy skin
Microcirculation
Dermis

Sulphated polysaccharides
from Porphyridium cruentum
WHY ARE THEY BENEFICIAL FOR SKIN HEALTH?
Heparin sulphate is the main sulphated glycosaminoglycan present in the epidermis. However, sulphated marine polysaccharides are potentially very good active ingredients for mimicking the sulphated glycosaminoglycans of the epidermis.
Research has therefore been carried out into the biological activity that a natural sulphated polysaccharide from microalgae could have on the structures of the epidermis and reconstructed human skin.
PORPHYRIDIUM EPS, AS FOUND IN SCIENTIFIC LITERATURE…
Sulphated exopolysaccharides (EPS) from the red microalgae Porphyridium cruentum have demonstrated activity on different biological mechanisms.
Indeed, in vitro studies have shown that these EPS were capable of significantly reducing the activity of hyaluronidase, on the one hand, and of reducing the activity of elastase, on the other.
Inhibition of elastase by EPS may not only allow greater permanence of elastin, but also of collagen and many other proteins essential for the skin. Furthermore, the strong inhibition of hyaluronidase activity achieved by EPS can help prolong the integrity of hyaluronic acid and the skin’s natural moisture balance.

The polysaccharides from Porphyridium cruentum and other Porphyridium species (and their oligomers obtained by microwave degradation) have an interesting antioxidant power. They combat reactive oxygen species produced under the impact of strong light radiation (antioxidant activity).
In addition, the inflammation and irritation of the skin resulting from the action of chemicals, excessive sun exposure and other biochemical and environmental factors can also be counteracted by EPS.
Studies have shown that the topical application of sulphated polysaccharides has a positive effect on the regeneration of the epidermis and its adhesion to the dermis, which could improve the surface topography of dry or mature skin and increase the long-lasting effect of moisturisers.
Porphyridium cruentum EPS appear to be good candidates for use in cosmetics or pharmaceutical formulations. They are used as an anti-ageing, protective, moisturising, emollient, lubricating and anti-inflammatory agent for all skin types, both to preserve the beauty and vitality of young, healthy skin and to treat those affected by a certain type of disorder.
Based on these results, scientists have suggested the use of Porphyridium cruentum EPS as an active ingredient in cosmetic formulas because of their excellent moisturising power and to maintain a healthy-looking skin.
Ridium ®
Skin Algae THERAPY
Ridium® is unique in the world of cosmetics. Its main ingredient (99% of the composition) comes from the natural extract of the marine microalgae Porphyridium cruentum.
The marine algae Porphyridium cruentum synthesises polysaccharides as a protective shield. Ridium® is composed of this concentrate of active polysaccharides, which form a protective film when applied to your skin.
The process used to obtain the active polysaccharide concentrate is a unique, innovative and patented biotechnology process, exclusive to Xelliss, thereby making Ridium® unique.
Ridium® provides a dual treatment: a short-term micro-lifting effect with each application and a long-term repairing effect (cell regeneration) after 30 days of use.
1. Micro-lifting effect with each application thanks to its great capacity to hydrate* the skin, creating firmness.
2. Regenerating and repairing (anti-ageing) effect after one month of use, which allows cell regeneration to reduce the appearance of fine lines and wrinkles and improve the skin’s texture, tone and luminosity.
*upper layers of the epidermis
Regenerating and repairing treatment with immediate micro-lifting effect.
Immediate Micro-lifting effect
1 day
Regenerating and repairing effect (anti-ageing)
30 days

99% active ingredient
Unique, pure, premium



XELLISS’ TECHNOLOGICAL PROCESS
Bio-cultivation in a closed and controlled environment.
A special process for production of the active ingredient.
ACTIONS
Active ingredient suitable for all skin types
Moisturising
Anti-ageing
Antioxidant
Anti-irritation
Immediate micro-lifting effect
Regenerating and repairing effect (anti-ageing)
Ridium® and its actions
ANTI-AGEING
EPS from the Porphyridium species inhibit the activity of the elastase and hyaluronidase enzymes. The inhibition of elastase by EPS may not only result in greater preservation of elastin, but also of collagen and many other proteins that are essential for the skin. In this way, EPS improve the skin’s elasticity and firmness.

HYDRATATION
The significant inhibition on hyaluronidase activity achieved by EPS can help to prolong the integrity of the hyaluronic acid and the natural hydration of the skin. In addition, the natural resistance of EPS to the action of hyaluronidase is a great advantage for their use as a filler in various beauty treatments. The excellent hydration capacity of sulphated polysaccharides makes them natural skin moisturisers. Furthermore, by inhibiting the enzymes involved in the skin’s degradation process, sulphated polysaccharides are an excellent biological lubricant with characteristics superior to those of hyaluronic acid


ANTIOXIDANT
They help to protect our cells from free radical damage, thus contributing to the prevention and reduction of age spots. Polysaccharides are valuable anti-ageing active ingredients.
ANTI-IRRITATION
Inflammation and irritation of the skin resulting from the action of chemicals, excessive sun exposure and other biochemical and environmental factors can also be countered by EPS.

Ridium® cosmetics test results A MULTIFUNCTIONAL EXTRACT!
Results of the cosmetics test measures carried out directly on the Ridium® active ingredient:
IN VIVO TESTS
Increase in hydration (panel of 50 people, after 1 month of application twice a day: + 5%).
Increase in firmness (panel of 50 people, after 1 month of application twice a day: + 29%).
IN VITRO TESTS
Significant reduction of reactive oxygen species (antioxidant activity) demonstrated.
Anti-inflammatory activity demonstrated.
Anti-pollution activity demonstrated. Detoxifying activity demonstrated.
IN VIVO COSMETICS TEST
RELATING TO SAFETY OF USE
Non-irritating, very good skin tolerance (cosmetics test on a panel of 12 people).
Non-allergenic (cosmetics test on a panel of 67 people).
Basic molecular structure
Xylose is the main sugar, followed by galactose and glucose. Mannose, fucose, arabinose and rhamnose are also present in minor percentages.
The «R» in the diagram may be a variable functional group, such as hydrogen, sulphate, galactose or xylose.
Details of the active ingredient used in Xelliss’ Ridium®
A 99% CONCENTRATION OF ACTIVE INGREDIENTS
It is an active gel comprising a purified concentrate of extracellular sulphated polysaccharides, secreted by the marine phytoplankton Porphyridium cruentum during its cultivation. It is a viscous, opalescent and colourless gel.
A UNIQUE AND COMPLEX MOLECULAR STRUCTURE
The product contains various sulphated polysaccharides of heterogeneous composition, a complex mixture of macromolecules with various biological properties.
GMO-FREE AND GUARANTEED COMPOSITION OF NON-ANIMAL ORIGIN
Recently, the use in cosmetics of collagen and gelatine, derived from animals such as cows and pigs, has become increasingly unpopular for reasons of health risk and ethical or religious motivations. Natural sulphated polysaccharides produced in this way have the advantage of being of nonanimal origin.

How to use Ridium®
INSTRUCTIONS
FOR USE
On previously cleansed skin, apply to the face, neck or areas of the face to be treated. Spread a small amount of product until a thin layer is obtained.
Leave to penetrate in order to observe the lifting effect. Effect visible from the first application.
The product adheres evenly to the skin’ s surface for a gentle lifting effect. It leaves the epidermal surface extremely soft and smooth, giving an immediate glamorous appearance.
Non-greasy, Ridium® penetrates quickly and is suitable for all skin types.
Use morning and/or evening.
PACKAGING
30 ml dropper bottle

ACTIVE INGREDIENT
Purity of the active ingredient, a unique quality.
Concentration of the active ingredient.
INGREDIENTS
WATER, EPS PORPHYRIDIUM CRUENTUM, GLYCEROL, PHENOXYETHANOL, HYDROXYETHYL CELLULOSE – PLANT CELLULOSE.
Active ingredient tested under dermatological and ophthalmological control. Hypoallergenic, suitable for sensitive skin.
Suitable for vegans.
